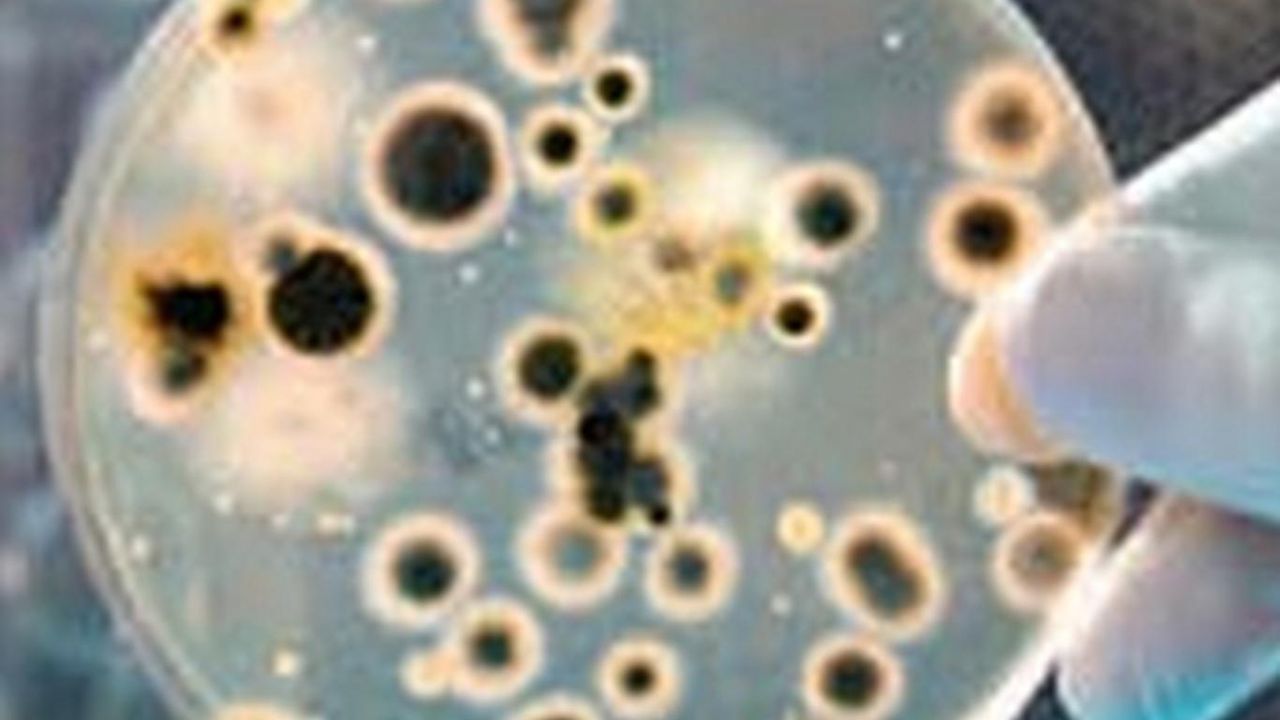

Kluge, ilaç direnci, tüberküloz-HIV koenfeksiyonu, sağlık hizmetlerine erişimdeki eşitsizlik ve yetersiz finansmanın krizi daha da büyüttüğünü ifade etti.
DSÖ’nün 12 Kasım’da yayımladığı "2025 Küresel Tüberküloz Raporu", 2024 yılında 1 milyon 200 binden fazla ölüm ve yaklaşık 10 milyon 700 bin vaka tespit edildiğini ortaya koydu.
“Önlenebilir bir hastalıktan ölümler vicdansızlık”
Raporda değerlendirmeleri yer alan DSÖ Genel Direktörü Tedros Adhanom Ghebreyesus, “Verem önlenebilir ve tedavi edilebilir olmasına rağmen her yıl 1 milyondan fazla can almaya devam etmesi vicdansızlıktır.” ifadesini kullandı. Ghebreyesus, 2030’a kadar tüberkülozu sona erdirmeye yönelik çalışmaların hızlandırıldığını belirtti.
Tüberküloz nedir?
Tüberküloz (TB), Mycobacterium Tuberculosis bakterisinin neden olduğu, hava yoluyla bulaşan bir akciğer hastalığı. Hastalık uygun tedaviyle iyileştirilebiliyor ve aşı ile önlenebiliyor.